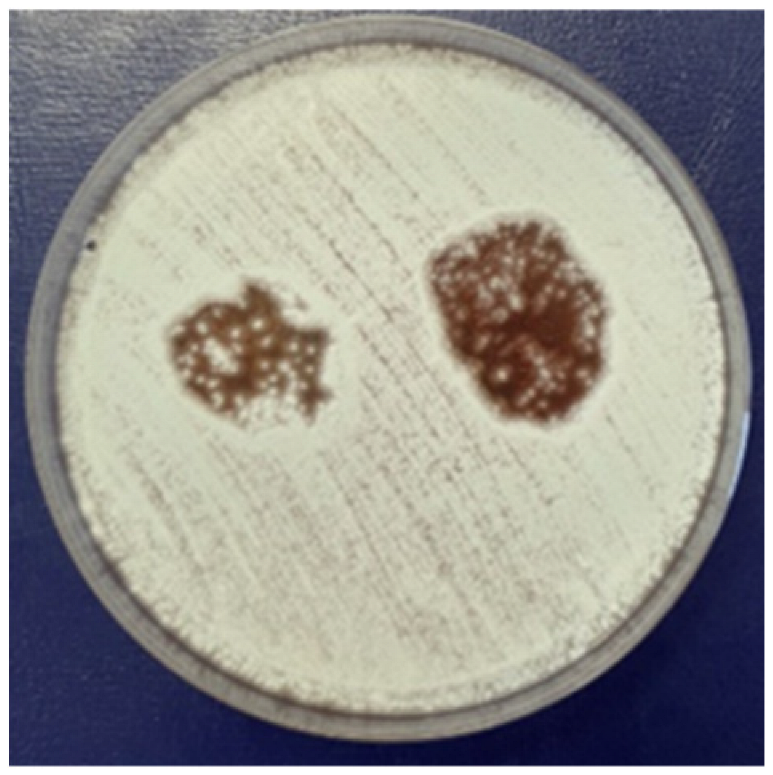
Coatings 15 00875 i009
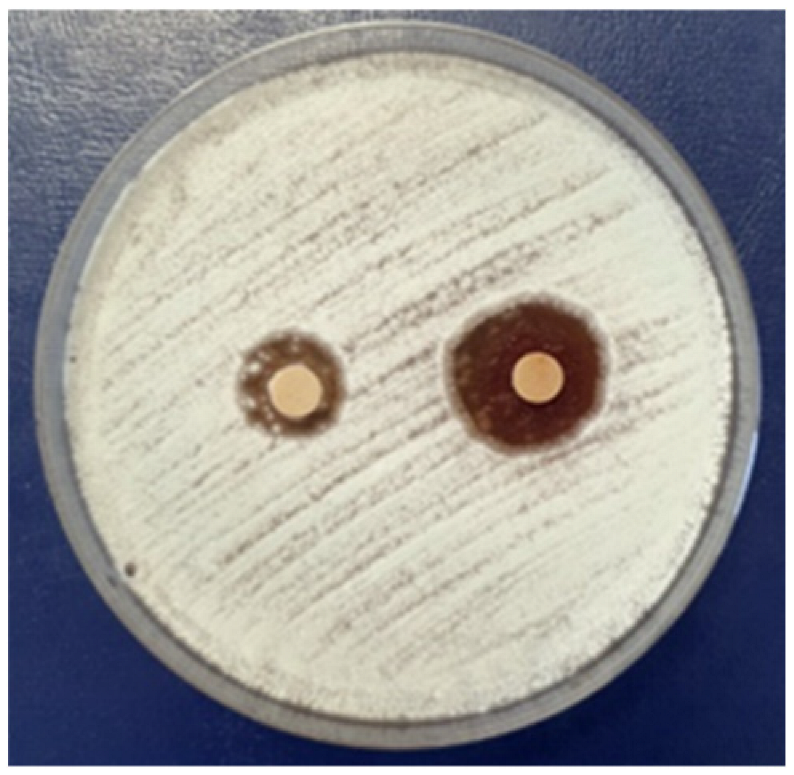
Coatings 15 00875 i011
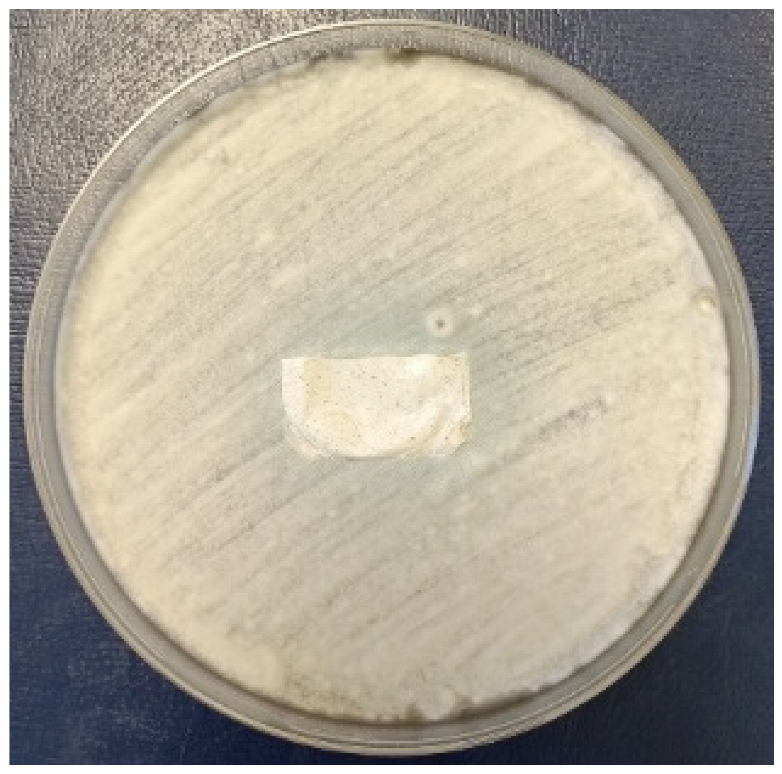
Coatings 15 00875 i017

Abstract
The development of sustainable and functional nanocomposites has attracted considerable attention in recent years due to their broad spectrum of potential applications, including wood preservation. Also, a global goal is to reuse the large volumes of waste for environmental issues. In this context, the aim of the study was to obtain soda lignin particles, to graft ZnO nanoparticles onto their surface and to apply these hybrids, embedded into a biodegradable polymer matrix, as protection/preservation coating for oak wood. The organic–inorganic hybrids were characterized in terms of compositional, structural, thermal, and morphological properties that confirm the efficacy of soda lignin extraction and ZnO grafting by physical adsorption onto the decorating support and by weak interactions and coordination bonding between the components. The developed solution based on poly(3-hydroxybutyrate-co-3-hydroxyvalerate) and lignin-ZnO was applied to oak wood specimens by brushing, and the improvement in hydrophobicity (evaluated by water absorption that decreased by 48.8% more than wood, humidity tests where the treated sample had a humidity of 4.734% in comparison with 34.911% for control, and contact angle of 97.8° vs. 80.5° for untreated wood) and UV and fungal attack protection, while maintaining the color and aspect of specimens, was sustained. L.ZnO are well dispersed into the polymer matrix, ensuring a smooth and less porous wood surface. According to the results, the obtained wood coating using both a biodegradable polymeric matrix and a waste-based preservative can be applied for protection against weathering degradation factors, with limited water uptake and swelling of the wood, UV shielding, reduced wood discoloration and photo-degradation, effective protection against fungi, and esthetic quality.
1. Introduction
Wood is a versatile material that has been used for centuries, both for indoor and outdoor applications. Its fibrous structure provides a high strength-to-weight ratio, esthetic appearance, renewability, durability, and thermal insulation properties—making it a worldwide preferred choice [1,2]. However, wood is inherently susceptible to various degradation pathways, significantly limiting its longevity and performance, particularly in outdoor or humid environments. These degradative processes include biological attacks by fungi (e.g., brown-rot, white-rot, soft-rot) and insects (e.g., termites, wood borers), physical weathering caused by moisture fluctuations (swelling and shrinking, cracking), and chemical degradation (primarily induced by ultraviolet radiation from sunlight, leading to lignin depolymerization, cellulose degradation, and surface discoloration) [3,4]. To mitigate these vulnerabilities and extend the service life of wood, wood preservation—a treating method using chemicals/biochemicals that can help to prevent or slow down the deterioration—is essential.
In addition to being a good consolidate, the preservative/protective coating must be compatible with the substrate (without modifying the color and appearance), but also reversible [5,6,7]. Traditionally, wood protection has relied heavily on synthetic polymer-based coatings derived from petrochemicals, such as polyurethanes, alkyds, and acrylics [8,9]. While effective in providing a barrier, these conventional coatings raise significant environmental and health concerns. Their production often involves both high energy consumption and the use of hazardous chemicals, including volatile organic compounds, which contribute to air pollution and human health risks during application and curing.
The development of sustainable and functional nanocomposites has gained significant attention in recent years due to their wide range of potential applications in fields such as packaging, biomedical devices, and environmental remediation. Poly(hydroxyalkanoates) (PHAs) are natural polyesters synthesized by bacteria that have been recently considered for many applications including medical devices [10], drug delivery carriers, and paper coatings, and intensively studied to replace conventional polymers [11]. Its thermoplastic properties allow their versatile processing into films, fibers, and coatings. The most used from the PHAs class is poly(3-hydroxybutyrate) with special physical and mechanical properties, similar with polypropylene, but less ductile [12]. PHAs are suitable for the use as wood protective coating due to their intrinsic hydrophobic nature, low acidity and biodegradability. Their efficiency was already demonstrated on stone [13]. Poly(3-hydroxybutyrate-co-3-hydroxyvalerate) (PHBHV) has emerged as a promising biopolymer due to its biodegradability, biocompatibility, and thermal stability. However, its application is often limited by its mechanical properties and processability, which can be enhanced by incorporating nanofillers, such as nanoparticles of inorganic materials [14,15,16]. PHBHV-based composites, particularly when combined with inorganic nanoparticles like ZnO, can significantly enhance the mechanical properties and crucially inhibit fungal growth on wood surfaces, acting as a robust protective barrier and improving the overall durability of the treated wood [2,17,18].
The biorefinery value can be increased by lignin extraction from the lignocellulose material. Lignin can be isolated by Kraft, soda, enzymatic, ionic liquid, ligno-sulfate methods, depending on pH, temperature, reagents, solvents, time, etc.; these parameters are very important for the structure and properties of extracted lignin [19]. Lignin is an aromatic polymer that makes up roughly one-third of lignocellulosic biomass and is produced in large amounts as a byproduct of biofuel and paper manufacturing. Each year, around 98% of the 100 million tons of lignin generated is discarded as low-value fuel, making this renewable polymer abundantly available at a very low cost. Due to its unique properties, lignin holds significant potential for a wide range of applications [20]. Polymeric films with lignin, native or modified, had improved thermo-mechanical, antifungal, and antimicrobial characteristics, and better water barrier properties especially with hydrophilic matrixes [21,22,23].
In the context of low fossil feedstock and the necessity to reuse the high volume of waste, lignocellulosic biomass, as a possible source of chemicals, presents the advantages of abundance, availability, and composition. Spent mushroom substrate (SMS) represents a major proportion of agricultural waste considering that each ton of mushroom generates a three-to-five times higher amount of SMS, throughoutthe year unlike conventional crops that are season dependent [24,25,26]. All this waste is not economically exploited, mainly being landfilled, and SMS valorization is a key factor for developing the circular economy model in the mushroom industry. SMS is formed by plant cell wall components (lignin, hemicelluloses, cellulose) like sawdust, wood chips, ground corn cobs, cottonseed meal, gypsum, etc. [27,28]. It contains also extracellular fungal enzyme, fungus mycelia, proteins, minerals, or diverse carbohydrates [29]. Isolated cellulose, together with hemicellulose, can be used for ethanol production, enzymes, or chemicals extraction. Spent mushroom substrate, with its unique features and environmentally friendly applications [19,25,30], has recently gained attention as a renewable and cost-effective source for extracting lignin. Soda lignin, a byproduct of the alkaline pulping process, has proven to be a suitable candidate for nanoparticle grafting due to its high reactivity and availability, making it suitable for chemical modification and integration into composite materials. The use of mild grafting methods, which avoid the harsh chemical reagents and conditions typically used in traditional grafting techniques, can preserve the structural integrity of the lignin while enabling effective nanoparticle attachment [31].
Zinc oxide (ZnO) nanoparticles, with their unique combination of optical, electronic, and antibacterial properties, have been explored extensively for incorporation into polymer matrices to enhance the functionality of the resulting nanocomposites [32,33,34]. The synthesis of ZnO nanoparticles, often carried out through various methods like sol–gel or hydrothermal processes, requires careful control of their size and morphology to ensure desirable properties in the composite [35]. In this regard, grafting ZnO nanoparticles onto lignin, a complex and abundant biopolymer derived from biomass, can offer a dual advantage. Lignin not only acts as a natural polymer matrix but also possesses a rich array of functional groups that can serve as effective anchor sites for nanoparticle attachment, thus improving the interfacial adhesion between the filler and polymer matrix. Lignin nanomaterials can be considered promising solutions with advantages of structural diversity and biodegradability to fossil-based materials for added-value applications, like antioxidants, biomedical, food packaging, technical items, etc. [36,37]. By incorporating grafted ZnO–lignin nanoparticles into the PHBHV matrix, a nanocomposite with enhanced mechanical and antimicrobial properties can be obtained. The presence of ZnO may improve the composite’s antifungal activity and UV protection, while the lignin can offer both reinforcement and biodegradability. Moreover, such an approach aligns with the growing interest in the utilization of bio-based and environmentally friendly materials, contributing to the development of green nanocomposites with multifunctional properties.
Under this context, this paper aims to investigate the mild grafting of ZnO nanoparticles onto soda lignin extracted from spent mushroom substrate and to explore the subsequent incorporation of the ZnO–lignin nanocomposites into PHBHV matrices. The structural and functional properties of the resulting polymer nanocomposites as efficient preservative coatings for wood surface, with a focus on their wetting performance, UV stability, and antifungal activity, will be investigated and discussed.
2. Materials and Methods
2.1. Lignin Extraction from Lignocellulosic Biomass
Lignin was extracted from the spent mushroom substrate (from the cultivation of Ganoderma mushrooms, with depleted mycelium and depleted substrate—SMS) by a method adapted from [38]. SMS was first washed and dried for 30 days at room temperature; then, the biomass was grounded at a maximum size of 0.5 mm. The alkaline extraction of lignin consists of dispersing the biomass (12 g) into a 6% NaOH solution (100 mL) (Chimreactiv, Bucharest, Romania) and heating the dark-brown suspension at 150 °C for 1 h, with a speed of 500 rpm. After cooling, 150 mL distilled water and 40 mL of sulphuric acid (H2SO4 98%) (Merck KGaA, Darmstadt, Germany) were added to the liquid fraction resulted after vacuum filtration. The change in color, from dark brown to yellow brown, highlights the precipitation of hydrophobic lignin. The resulting suspension was then heated at 110 °C for 1 h, cooled, and filtered. The precipitate (soda lignin) was washed three times with distillated water, then dried in an oven at 60 °C for 24 h. The extracted lignin, with a 17.5% yield, was sprayed with 10 mL of a 6% solution of sodium sulphite (Na2SO3) Chimopar, Bucharest, Romania) and dried at 110 °C for 24 h. The brown powder, soda lignin—L, was purified by dispersion in deionized water by adjusting the pH to 12 using NaOH 1 M, sonication for 3 h, separation of the solid by centrifugation, and drying.
2.2. Lignin Decoration with ZnO Nanoparticles
The suspension of 0.5 g of purified lignin dispersed into 10 mL of 5% hexahydrate zinc nitrate (Zn(NO3)2∙6H2O) Lach-ner, Ltd., Neratovice, Czech Republic) was sonicated in an ultrasonic bath for 2 h, at room temperature. Then, 0.05 g citric acid and 1 mL of ethylene glycol were added and the mixture was homogenized by magnetic stirring for 2 h. After adjusting the pH to 7 using an ammonia solution (Carl Roth GmbH, Karlsruhe, Germany), the mixture was heated to 80 °C for 8 h. Thus, the forming of ZnO nanoparticles and their grafting to lignin surface resulted (L.ZnO), the dried material having a mass of 0.838 g.
2.3. Wood Specimens’ Treatment
Specimens of oak wood (Quercus robur L.) naturally dried for 5 years were used as support for testing the consolidate solution. The dimensions of the wooden samples were 20 × 20 × 6 mm3 (L × l × h), cut with an electric saw, without polishing the surface. The determined initial humidity of the wood was 8.5% (using an Extech M0280 pinless moisture, (Extech Instruments Corporation, Waltham, MA, SUA) model). Poly(3-hydroxybutyrate-co-3-hyroxyvalerate) (PHBHV) containing 2% HV (Good Fellow Cambridge Limited, Huntingdon, UK) was first dissolved in chloroform at 60 °C by stirring for 6 h in a closed round-bottom flask, in a laboratory reflux plant. The synthesized L.ZnO nanoparticles were added in PHBHV solution (0.2%) and the mixture was homogenized into an ultrasonic bath (Bandelin Electronic GmbH & Co. KG, Berlin, Germany) at room temperature for 2 h. The obtained solution was applied onto the wood specimens by brushing 3 times on each face of the sample; the specimens were then dried at room temperature for 24 h before testing and analyzing the consolidation effect in comparison with the control, which is the untreated wood sample.
2.4. Testing Methods
Lignin content was analyzed for both the initial SMS sample and the remaining sample after extraction. The procedure consisted of the following: mixing 1 g of the sample with ethanol (67 mL) for 4 h and left overnight; the precipitate was separated by filtration, washed with distillated water and dried for 24 h at 60 °C; a 72% solution of concentrated H2SO4 ((Merck KGaA, Darmstadt, Germany) was added to the precipitate in an ice bath and stirred for 2 h; water was added to the mixture and then condensed in a reflux plant; the separated precipitate was dried at 105 °C and weighted. The lignin content (%) was calculated as the ratio between the amount of the resulting lignin and the initial sample.
Fourier Transform Infrared Spectroscopy (FTIR) with attenuated total reflection (ATR) mode was recorded using a GX-type FTIR spectrometer (Perkin Elmer, Waltham, MA, USA), from 4000 to 400 cm−1, with a resolution of 4 cm−1, by accumulating and mediating 32 spectra.
Raman spectra were obtained with a Rigaku portable analyzer (Xantus-2, Rigaku, The Woodlands, TX, USA), with a 785 and 1064 nm stabilized laser, and a resolution of 4 cm−1. Data processing was achieved using an Opus 7.0 software from Bruker Optics GmbH (Ettlingen, Germany).
X-ray Photoelectron Spectroscopy (XPS) analysis was performed on a K-Alpha equipment with a monochromatic Al Kα source (1486.6 eV) and working in a vacuum base pressure of 2 × 10−9 mbar (Thermo Scientific, Waltham, MA, USA). Charging effects were compensated with an argon ion-based flood gun, and binding energy was calibrated by placing the C 1s peak at 284.8 eV as internal standard. Deconvolution of high-resolution elemental peaks was performed using a Smart background subtraction, utilizing Gaussian–Lorentzian convolved algorithm. The pass energy for the survey spectra was set at 200 eV, while for the high-resolution spectra it was 20 eV.
UV-Vis absorption spectroscopy was achieved with a PG 60 UV-VIS spectrophotometer (PG Instruments Limited, Leicestershire, UK) over a range of 200 to 500 nm, in 1 cm matched quartz cells, with a resolution of 1 nm, and a 0.3 nm/s scan rate.
Environmental scanning electron microscopy (ESEM-FEI Quanta 200, Eindhoven, Netherlands) was utilized to evaluate the samples’ morphology, with a magnification ranging from 50× to 100,000×. ESEM images were achieved using a low vacuum mode, without any covering of the materials.
Transmission Electron Microscopy (TEM) analysis was achieved using a Tecnai F20 G2 TWIN Cryo-TEM (Thermo Fischer Scientific, Waltham, MA, USA) at an accelerating voltage of 200 kV. The sample was dry sectioned using a Leica EM UC7 ultramicrotome (Leica, Wetzlar, Germany) at a rate of 0.2 mm/s and a cutting step of 200 nm. The sections were then applied electrostatically onto formvar 400 mesh copper grids and analyzed in BF-TEM (bright field TEM) mode.
X-ray diffraction analysis (XRD) has been achieved by using a Rigaku Ultima IV diffractometer (Rigaku Corporation, Tokyo, Japan), which used the following parameters: Cu Kα radiation (λ = 1.5406 Å), 40 kV, and 40 mA. For the diffractograms, a 2θ range from 5° to 100°, and a scanning rate of 1°/min, have been followed.
Thermogravimetric analysis (TGA) was performed on a TA-Q5000IR (TA Instruments, New Castle, DE, USA) with nitrogen as the purge gas with a flow rate of 50 mL/min. Duplicate samples weighing between 10 and 13 mg were heated from room temperature to 750 °C at a constant heating rate of 10 °C/min.
The wavelength dispersion X-ray fluorescence spectroscopy (WDXRF) used a Rigaku Supermini 200 (Rigaku Corporation, Tokyo, Japan), equipped with an X-ray tube featuring a Pd anode and 200 W power. Precise and comprehensive results from the spectroscopic examination were achieved using the Rigaku SQX fundamental parameters software (ZSX version 2019).
The antifungal activity of the samples was determined by the diffusion method in Petri plates with sterile Sabouraud agar medium (Scharlau dehydrated powder (g/L); 40, glucose; 10, peptones; 15, agar) and potato dextrose agar (Scharlau dehydrated powder (g/L); 20, glucose; 20, potato peptones; 15, agar). The culture media were sterilized for 20 min at 121 °C, cooled at room temperature and then turned into Petri dishes. The L and L.ZnO powders were solubilized in DMSO (Merck KGaA, Darmstadt, Germany) (stock solution: 0.1 g powder per 1 mL DMSO). The fungal inoculum (Aspergillus niger and Penicillium chrysogenum) was represented by a suspension in sterile physiological water, made from a fresh culture of 48–72 h, with a density of 1–3 × 105 CFU/mL, adjusted nephelometrically (SD2300 McFarland standard 0.5 = 1.5 × 108 CFU/mL, ProLab Diagnostics, Bucharest, Romania) and spectrophotometrically by measuring the absorbance at 530 nm. The samples (suspensions in DMSO) were inoculated, 50 and 100 µL per spot or disk, onto the fungal medium (Scharlab S.L., Barcelona, Spain). The antifungal activity was tested also for films based on PHBHV, with and without the consolidate, and for coated and control wood specimens. The testing was carried out in Petri dishes with a specific agar medium, PDA (potato dextrose agar), previously inoculated with the same tested microorganisms, and incubated at 28 °C for 72 h to 96 h.
The retention of the wood preservative was calculated as the mass percentage increase (%), by weighing the samples before treatment and after covering the specimens with the polymeric coating, in grams [39]. Each sample was analyzed in triplicate in order to study the treatment efficacity.
Chromatic parameters (Lx*, ax*, bx*) were determined in triplicate with a CR-410 colorimeter (Konica Minolta, Tokyo, Japan) in the CIE L*a*b* system (CIE 1986) [40], with C illuminant and 2° observer. The total difference color was calculated using the changes in the chromatic parameter in comparison with the untreated specimen, using formula (1):
where ΔL is the difference in lightness (Lx* treated wood − Lx* untreated wood), Δa is the difference in red–green tint (ax* treated wood − ax* untreated wood), and Δb is the difference in yellow–blue tint (bx* treated wood − bx* untreated wood).
The contact angle was measured for each wood specimen in order to evaluate the hydrophobicity improvement when applying the polymer coating. The test was made at 21 °C, in duplicate and reported as average. The droplet was photographed after placing it on the straight wood surface and the values were obtained using the DropAnalysis plugin LB-ADSA from ImageJ (version 1.54t) according to [41]. Also, the variation in the contact angle was measured during 1 h.
In the water absorption test, the amount of water absorbed by each sample (dried at 103 °C, until constant mass) immersed in an aqueous medium for 24 h, at room temperature, was determined by weighing the specimens, treated and untreated, before and after the procedure.
The humidity of the specimens was also determined. After the immersion in water for 0.5 h, the samples were dried at 100 °C for 1 h and at room temperature for 24 h. The humidity (%) was calculated based on the masses of the wet and dried samples (g).
The UV protection of the consolidant solution was tested by an artificial aging test where the specimens were irradiated using a mercury-ARC lamp of 375 W/cm2 (Helios Quartz, Istanbul, Turkey), for up to 420 h. The irradiation effect was analyzed by chromatic changes, FTIR analysis, and contact angle measurement.
3. Results and Discussions
3.1. The Extraction and ZnO Decoration of Soda Lignin
The alkaline extraction method, at high temperature, ensures a relatively high yield of separating lignin from hemicellulose and cellulose, the main components of SMS, using low amounts of common chemicals and energy. The structural, morphological, compositional, and antifungal properties of extracted lignin and of the resulting lignin hybrid were analyzed in order to confer proper characteristics to biodegradable films based on PHBHV.
The lignin extraction efficiency was first analyzed by the difference between the tested lignin content for the spent mushroom substrate and the remaining part of the SMS after extraction. SMS had a lignin content of 19.5%, while, after extraction, the determined ratio was 2.26%, highlighting the proper removal of lignin by the used method.
The analysis of the functional group of control (SMS), the remaining solid fraction (containing cellulose and hemicellulose), and the extracted lignin part was achieved, the FTIR spectra being presented in Figure 1a. As compared to neat SMS, after the alkaline extraction, more changes in the infrared spectrum can be observed. The specific hydroxy, methoxy, and syringyl peaks are present in all the three samples. The more intense peak of approx. 3300 cm−1 recorded for soda lignin can be due to introducing more hydroxyl groups during the alkaline reaction. Some small amounts of remanent cellulose and hemicellulose, incompletely separated from lignin, can be highlighted based on the specific peaks that appear at 1786, 1349, and 1069 cm−1. The spectrum of extracted soda lignin is comparable with the literature data, mentioning the specific absorptions from 1561 cm−1 (aromatic skeletal vibration), 1344 cm−1 (C-H bending in G ring condensed), 1230 cm−1 (C-C, C-O, C=O stretching), 1126 cm−1 (C-O stretching), 940 cm−1 (C-O stretching or -CH=CH- out of plane bending), and 830 cm−1 (C-H out of plane bending) [42,43]. The absence of absorption bands from 2600 to 2650 cm−1 and 1703 cm−1, characteristic for S-H stretching thiol and for carbonyl, respectively [44], sustain the obtaining of soda lignin during the extraction from SMS.
Figure 1.
Structural analysis by FTIR (a) and Raman spectra of initial and final products (b).
Based on the FTIR spectrum of the L.ZnO hybrid, the presence of ZnO into the lignin structure is evidence of some possible weak interactions between the inorganic nanoparticles and the polymer chain, showing peaks’ shifts or changes in intensity in the phenolic hydroxyl group, C-O stretching, and aromatic regions due to the interaction of ZnO with these groups in the lignin structure. The 3300 cm−1 to 3400 cm−1 broad peak associated with the O-H stretching vibration of phenolic groups in the lignin has a decreased intensity by the ZnO decoration. The absorption from 1561 cm−1 is displaced to 1582 cm−1, the peak from 1344 is shifted to 1422 cm−1, and the one from 940 to 957 cm−1. These changes can reflect some interactions between the components, hydrogen or coordination bonding is established besides the physical adsorption of the inorganic nanoparticles on the soda lignin surface. So, a stronger interface is formed by the two components.
The strong peak from 600 cm−1 to 400 cm−1 appears due to Zn-O-Zn vibration and due to the bonding between the ZnO surface and the phenolic or hydroxyl groups in lignin.
Raman spectra sustain the structural observations. SMS presents the characteristic peaks corresponding to lignocellulosic material, Figure 1b and Table 1. The C-O-C and C-H deformation peaks indicate significant polysaccharide presence (cellulose and hemicellulose), while the strong lignin-associated peaks (490 cm−1, 1591 cm−1) sustain the lignin content. The peak from 1860 cm−1 could be due to oxidized lignin derivatives or fungal metabolites.
Table 1.
Raman interpretation for SMS.
L.ZnO has strong peaks at approx. 393, 499, 584, and 1322 cm−1, all linked to the lignin content, as can be observed in Figure 1b. The peak from 1860 cm−1 also appears, indicating a higher chemical modification of lignin. The decoration with ZnO is attributed to 374, 413, and 565 cm−1 peaks, which match to the A11(TO), E11(TO), and E11(LO) modes. A shift of 4 cm−1 can be observed for 1360 cm−1 peak of lignin. This, in addition to the peak from 1240 cm−1 (shift of C-O stretching in lignin) which could be the proof of weak interactions (hydrogen bonding or electrostatic forces), is a physical adsorption of ZnO to the decorating support.
To further investigate the nature of the interactions between ZnO and soda lignin in the obtained hybrids, the high-resolution XPS survey was recorded and the elemental peaks were analyzed. Figure 2 shows the survey spectra of soda lignin and L.ZnO, the O 1s and C 1s spectra of both powders, and Zn 2p1 and Zn 2p3 peaks for the grafted ZnO particles on lignin surface. While the soda lignin survey contains the peaks of Na, O, and C, the presence of the characteristic peaks of C, O, and Zn elements in the survey of L.ZnO indicates the successful preparation of the composite.
Figure 2.
XPS spectra of the samples. (a) survey spectra of L and L.ZnO; (b) Carbon 1s spectrum of sample L; (c) Oxygen 1s spectrum of sample L; (d) Zinc 2p spectrum of sample L.ZnO; (e) Carbon 1s spectrum of sample L.ZnO; (f) Oxygen 1s spectrum of sample L.ZnO.
The C 1s XPS spectrum of soda lignin could be decomposed into three subpeaks: the peak at 284.74 eV was attributed to the C-C and C-H groups, the peak centered at 286.11 eV was assigned to -C-O-C groups, while the peak from 288.89 eV can be attributed to -O-C=O functionalities [45,46]. A slight shift in the two peaks is observed in the case of L.ZnO, together with an increase in binding energy from 288.89 eV to 290.14 eV. The previous observed interactions from FTIR and Raman analysis are sustained by the XPS results. Besides physical interactions, carbonyl coordination with Zn is achieved.
Soda lignin O 1s peak deconvolution showed the characteristic peaks, from 531.39 and 534.23 eV attributed to surface hydroxyls/adsorbed water, and the oxygen in carbonyls or esters from soda lignin structure [47]. The peak from 529.89 eV appears probably due to soda lignin contamination, considering its provenience. After grafting ZnO on the lignin surface, two peaks are identified: at 530.02 eV assigned to O from the metal oxide and 533.63 eV specific for OH groups absorbed on the surface. In conclusion, the higher binding energy confirms that the oxygen in carbonyls or esters could be involved in strong hydrogen bonding with ZnO [46].
The C/O atomic ratio determined for soda lignin and L.ZnO showed an increase from 1.3126 to 1.9856. The possible causes of this enhance can be related to the coordination established with ZnO that can reduce the surface oxygen signature and the covering of lignin with metal ion nanoparticles, making the XPS signal more carbon dominated. The presence of Zn in the composition is confirmed by the Zn 2p atomic percentage as 6.3% (Zn 2p1 md Zn 2p3), in accordance with other studies [21].
The UV-Vis absorption spectra of soda lignin and a lignin–ZnO hybrid exhibit two distinct peaks, primarily due to the UV absorption of the lignin structure and any contributions from ZnO, as shown in Figure 3.
Figure 3.
UV absorbance of lignin and L.ZnO.
Soda lignin extracted from SMS presents the characteristic absorption at 280 nm, with moderate intensity, that, according to the literature, can be attributed to guaiacyl (G) units of soda lignin [30,44]. In addition to carbonyl groups, lignin contains phenolic hydroxyl groups and other aromatic ring systems (derived from precursors of p-coumaryl, coniferyl, and sinapyl alcohols), which exhibit stronger and broader absorption bands, especially in the range of 220–280 nm. The exact position and intensity of these bands depend on the degree of substitution, electron-donating or electron-withdrawing effects, and the degree of conjugation. The peak around 280 nm is typical associated with π → π* transitions of aromatic rings and contributions from conjugated carbonyls. Except for π → π* transitions of aromatic rings, an n → π* transition of unconjugated carbonyl groups generally occurs in the region of 280–300 nm. These transitions are generally weaker in intensity compared to the π → π* transitions but are nevertheless visible and diagnostically important. In conjugated systems (e.g., carbonyls conjugated to aromatic rings or C=C double bonds), this transition shifts to longer wavelengths (bathochromic shift), potentially occurring above 300 nm, due to the delocalization of π electrons.
For grafted nanoparticles, the peak is broadened in the presence of ZnO that can modify the conformation of lignin molecules. This can lead to changes in the electronic transitions of lignin, resulting in broader absorption bands. The specific peak of ZnO that should appear at approx. 341 nm, due to absorption characteristics for the oxide, for L.ZnO is shifted at 361 nm as a consequence of the grafting of nanosized ZnO to the highly functionalized lignin surface [48]. The sharp-peak characteristic for grafted ZnO to the polymeric surface can be considered an indicator of the nanometric size of particles and their narrow size distribution.
The presence of ZnO in the hybrid composition could be highlighted also by XRF analysis, a non-destructive analytical method that is used to identify the elemental composition of materials. Qualitative data obtained from XRF shows that Zn is present in the obtained sample, as shown in Figure 4. The specific bands of Zn are present in the recorded spectrum. The quantitative data, added as an insert to the spectrum, reflects the maintained composition in minerals from SMS. The spent mushroom substrate is, aside from an organic-rich material, a nutrient profile enriched in nitrogen, phosphorus, potassium, calcium, sulfur, sodium, etc. [49,50]. No other new elements were identified, so the considered synthesis led to a high purity of materials.
Figure 4.
WDXRF results for L.ZnO sample.
The morphology analysis performed by ESEM, Figure 5, shows the soda lignin’s specific rough, irregular surface with fibular structures, with some degree of roughness, typical for a material that is rich in hydroxyl and phenolic groups. The porosity is often due to lignin’s inherent structure, which is designed to contribute to the strength and rigidity of plant cell walls [43]. Lignin is a complex polymer with a highly branched and heterogeneous structure, resulting from its extraction from the spent mushroom substrate. Its surface is typically porous, with a non-uniform and somewhat amorphous morphology. Aggregated particles can also be observed.
Figure 5.
SEM images of sample L at 1000× (a) and 5000× (b); SEM images of sample L.ZnO at 1000× (c) and 5000× (d); complete covering of L surface with ZnO nanoparticles (e); 10,000× images with ZnO rod-shaped crystals (f).
When ZnO nanoparticles are incorporated into soda lignin, significant changes in the SEM morphology are expected due to the interactions between the ZnO particles and the lignin matrix [51]. For the synthesized L.ZnO hybrid, the nanoparticles are dispersed on the surface of the lignin. Small, spherical, or irregularly shaped structures ranging from 100 nm to a micron in size are highlighted. The main forms that can be observed are nano- or micro-sized clusters formed by ZnO that partially and uniformly cover the soda lignin surface. The lignin surfaces that were not totally covered by ZnO nanoparticles probably resulted from the grinding prior to analysis. From Figure 5e, the fully covered lignin particles can be observed. The lignin surface becomes more compact, probably due to the insertion of small ZnO particles into the interstitial spaces on the superficial structure and a strong interface formed through physical bonds with the soda lignin’s functionalities. Thus, a less porous hybrid material is obtained. ZnO rod-shaped crystals also characterize the hybrid morphology. Elongated structures with highly crystalline appearance, 40–150 nm width and up to 2 microns can be observed on the ZnO layer [52]. Each of these ZnO morphologies have unique characteristics that make them suitable for different applications based on their size, surface area, and crystallinity and will be analyzed.
The XRD analysis of SMS before lignin extraction and the obtained decorated lignin with ZnO nanoparticles, Figure 6a, reveals the morphology changes induced by the synthesis. SMS has more intense peaks located between 13 and 30°. The dominant peak at 2θ ≈ 22.6° strongly indicates the presence of cellulose, which is one of the major components of the lignocellulosic biomass. This peak corresponds to the (002) crystallographic plane of cellulose I, a common crystalline form in plant-derived biomass. A small peak is observed at approx. 20.4° corresponding to the (102) crystallographic plane of cellulose. Hemicellulose and lignin are generally amorphous, which means they do not show sharp peaks in XRD. Instead, they contribute to the broad hump in the diffractogram, observed around 2θ ≈ 16°. The presence of sharp peaks suggests a degree of crystallinity in the SMS, likely due to the arrangement of cellulose fibers. The crystallinity calculated based on the area below the crystalline peaks and the total area of crystalline and amorphous peaks is 72.74%, so SMS retains a high degree of crystallinity, mainly due to residual cellulose fibers, which could be relevant for several applications of reinforcing. XRD analysis reveals also several peaks between 30 and 40 degrees that could indicate the presence of inorganic minerals, possibly from residual soil or nutrients used during mushroom cultivation. Peaks around 30° could be associated with silicates, calcium carbonate (CaCO3), or calcium oxalate, which are commonly found in plant biomass. The peaks closer to 39.9° could correspond to crystalline quartz (SiO2) or other mineral impurities.
Figure 6.
(a) XRD spectra of spent mushroom substrate and the synthesized L.ZnO hybrid; (b) TGA/DTG curves of lignin and L.ZnO.
The XRD diffractogram recorded for the L.ZnO hybrid reveals a crystalline structure dominated mainly by ZnO-specific peaks. The analysis shows peaks at 31.8°, 33.7°, 38.8°, 48.1°, 56.7°, 63.7°, and 66.8° corresponding to (100), (002), (101), (102), (110), (103), and (200) ZnO planes [53,54]. The main characteristic peaks correspond to the wurtzite hexagonal phase of ZnO (JCPDS Card No. 36-1451), strongly suggesting the presence of ZnO in the synthesized hybrid. L.ZnO has a crystallinity index of 57.15% due to the high amorphous lignin fraction. Lignin also might hinder the crystallization of ZnO or form a composite structure with an altered diffraction pattern. The peaks observed at 2θ below 30° can be attributed to some traces of residual cellulose that were not removed during the purification stage. FTIR analysis confirmed the existence of some small amounts of remanent cellulose and hemicellulose, incompletely separated from lignin.
Thermal gravimetric analysis (TGA) was conducted to investigate the change in lignin thermal stability after grafting ZnO particles. The TGA and first derivative (DTG) curves presented in Figure 6b show a small initial mass loss for both powders up to ~120–150 °C, due to the evaporation of adsorbed water or volatile impurities [38,55]. The loss is slightly less pronounced in L.ZnO, possibly due to reduced hydrophilicity or better dispersion from ZnO. The main thermal degradation region for soda lignin, between 200 and 500 °C, can be associated with the following: cleavage of ether bonds (β-O-4 linkages), decomposition of phenolic and aliphatic structures, and carbonyl/COOH group degradation [56]. For L.ZnO, the Tmax (peak of derivative curve) of this degradation stage is shifted to a higher temperature, from 331 to 371 °C. ZnO moderates organic degradation probably through the coordination with lignin’s functional groups. After 500 °C, soda lignin shows continued weight loss up to ~700 °C, but flattens, and L.ZnO shows a delayed and less intense weight loss and remains more stable. The final residue increases from 48.94% to 57.37%, also confirming the better thermal resistance and presence of inorganic ZnO residue.
Based on the complex characterization study on soda lignin almost completely extracted from SMS (lignin content decreases from about 20% in spent substrate to 2.26% in the extracted solid material), it can be concluded that the alkaline method was efficient for lignin isolation. The techniques used, FTIR, Raman, XPS, XRF, UV spectroscopy, XRD, ESEM, and TGA, showed the specific characteristics of lignin and were also used as a comparison to evaluate the ZnO decoration. Structural analyses reflected a stronger interface between the hybrid components, with possible hydrogen or coordination bonding, in addition to the physical adsorption of ZnO nanoparticles on the soda lignin surface; the nature of the interactions between ZnO and soda lignin in the obtained hybrids were identified by recording the high-resolution XPS survey. These observations were sustained by XRD, the recorded diffractogram showing a crystalline structure formed by ZnO, with its specific peaks, and an amorphous lignin phase. The hybrid morphology was found to be more compact when decorating soda lignin with in situ-generated ZnO nanoparticles, mostly spherical and rod-shaped crystals, uniformly dispersed on the substrate surface. The interactions established between the organic and inorganic phases led to filled interstitial spaces and lignin pores.
In conclusion, the premise of a proper lignin separation and its decoration with ZnO nanoparticles was confirmed by the structural and morphological results, and the study could be continued by investigating the effect of the developed hybrid on wood preservation.
3.2. Characterization of Coated Wood Specimens
PHBHV-L.ZnO was studied as a coating for wood surface, considering it an environmentally friendly and biodegradable alternative to conventional coatings. Its application and performance depend on factors such as the intended use and exposure conditions, mainly weathering parameters like humidity, temperature, and UV irradiation. The application method (spraying, brushing, or dipping) could impact the smoothness and uniformity of the coating. Brushing is preferably used to apply the consolidate mainly because it can ensure an efficient and uniform covering of the substrate, even into the samples’ corners and cracks, and offers a relatively controlled balance between penetration depth and solvent evaporation [2,57]. Changes in performance were analyzed in comparison with the control wood sample, polymer coating, and lignin-treated wood.
3.2.1. The Retention of Wood Preservative
Preservative retention, an important factor that influences the wood’s characteristics, was calculated based on the masses before and after polymeric treatment, in triplicate, and the average values are presented in Table 2. A small increase in retention with adding lignin and L.ZnO is obtained. On one hand, the differences in the weight of the compounds could cause this increase; on the other hand, these preservatives are able to penetrate and fill the wood pores and, together with the polymeric solution, result in better surface isolation. The higher amount was obtained for the L.ZnO composition and better results are obtained for this consolidate.
Table 2.
Characteristics of control and treated wood samples.
3.2.2. Aspect and Morphology of Coatings
For practical application, the color and aspect of oak wood, which are usually already related to the age and annual ring width, has to be unchanged after applying the coating, Table 2. The prominent grain pattern and straight grain are present in all the samples. Coated specimens have a uniform texture, with fewer open pores. The polymer coating, with or without lignin-based particles, creates a smother surface, without imperfections when applied to wood. Soda lignin and L.ZnO hybrids appear on the SEM images as uniformly dispersed into the formed film, covered by the polymer matrix. Less pores are observed for all the coatings due to the penetration of the coating into the wood structure. No phase separation could be observed so the films presented a good interfacial compatibility between polymer and hybrids. By determining the color parameters (L*—luminosity; a*—green–red; b*—blue–yellow) and calculating the total color change, ΔEx *, the CIELab color system [40] has been applied to distinguish the color variations between coated and uncoated wood specimens. Identification of the variations in all the three color components is important. The total color difference that is highly recommended for use is not to exceed 5.0 ∆Ex* units, according to the standard variations. As reported in Table 2, the main changes in parameter values are given by the polymeric solution. When applying neat PHBHV coating, the sample becomes darker, with a ΔLx* value of −3.540, as previously observed [58]. The sealing of the pores, besides decreasing the lightness, also increases the a* value and decreases the b* parameter.
By introducing lignin particles into the system, due to its yellowish-brown tint, a higher change in yellowness can be observed, Δbx* = −1.43, and similar modifications in Lx* and ax*. Best results are obtained for using L.ZnO as consolidate when the sealing of the surface lead to a smaller darkening degree (ΔLx* of −2.99 units) and more reduced color variations for the green–red and blue–yellow parameters (Δax* of 0.55 and Δbx* of −1.09).
The total color difference, calculated according to Equation (1) for coated samples in comparison with the control wood specimen, has close values for all the three types of coatings. ΔEx* is 3.68 for PHBHV, 3.79 units for PHBHV.L, and 3.22 for PHBHV.LZnO, maintaining the color change into the tolerance range of the color shift.
Figure 7 shows the TEM image of PHBHV.LZnO that sustains the SEM observations. All four images show an organic matrix that appears as an amorphous electron-transparent or slightly gray background, with embedded darker regions, indicating the presence of L.ZnO nanoparticles.
Figure 7.
TEM image of PHBHV.LZnO at the magnitudes: (a) 500 nm; (b) 200 nm (c,d) 100 nm (different analyzed zones).
The nanoparticles seem well-dispersed, without significant agglomeration. The contrast and definition suggest they are well integrated into the matrix. They are not simply on the surface but appear embedded or semi-embedded in the organic matrix, indicating strong interfacial interaction between L.ZnO and PHBHV. The nanoparticles have dimensions between 30 and 75 nm, without any significant agglomeration. Core–shell-like structures could be observed where the center and edge areas of the composite presents significant black-and-white color differences, indicating that the ZnO particles are deposited on soda lignin surface and forms a hybridized structure with lignin functionalities and a polymer chain [59].
L.ZnO particles appear to blend into the surrounding matrix without a sharp, distinct border, suggesting physical bonding at the interface, and the ester groups (-COO-) and alkyl side chains of PHBHV are able to establish physical interactions with L.ZnO functionalities [16,60]. No phase separation or voids around particles could be observed in the composites.
As observed by the morphological characterization of specimens, it is highlighted that L.ZnO are well dispersed into the polymer matrix, and the PHBHV.LZnO film formed on wood changes its naturally rough, porous, and anisotropic surface to a smooth and less porous one. This improvement could limit water uptake and swelling of the wood, could ensure uniform UV shielding and reduce wood discoloration and photo-degradation, could impart a more effective protection against fungi or other microorganisms, and could improve the esthetic quality. This high-performance film can replace petrochemical-based coatings, aligning with sustainable-materials goals.
3.2.3. Hydrophobicity
One of the main targets of applying the consolidate treatment is increasing the hydrophobicity of the surface. Wood is naturally very susceptible to moisture due to its chemical composition (rich in hydroxyl groups), so sealing the pores and avoiding water penetration could increase wood durability and performance. To evaluate the treatment efficacity, coated-wood resistance to water was evaluated by water absorption and humidity tests, and contact angle measurements, as shown in Table 2 and Figure 8.
Figure 8.
Determination of the contact angle using the ImageJ software for the following: (a) wood-control sample; (b) treated with PHBHV; (c) treated with PHBHV.L; (d) treated with PHBHV.LZnO; (e) variation in contact angle’s value for each sample measured during an hour.
Wood-preservative retention can be well correlated with the decreased values of water absorption. The sample of oak wood considered in the study had a high capacity to absorb water when immersed and a high humidity value. Water absorption decreases by 32.4% when the wood is coated with PHBHV and by 38.3% when using PHBHV.L consolidate. As previously mentioned, the highest consolidate retention observed for PHBHV.LZnO is reflected by the lowest water absorption values, which decreased by 48.81% as compared to the control wood. Also, the humidity decreases in the same order.
The improvement of hydrophobicity can also be reflected by the contact angle (CA) measurement, as seen in Figure 8a–d. For a CA between 0 and 90°, the surface is considered hydrophilic (wettable) and for CA higher than 90° the material is non-wettable. The control wood specimen whose CA value was 80.5° did not support the variation test made for one hour; the water drop was adsorbed in the first 5 s, showing the high hydrophilicity, as previously demonstrated. All the three consolidated surfaces presented good hydrophobicity; the contact angles were higher than 95°, so the sealant capacity is very good. In Figure 8e, the variation in the contact angle for the coated wood samples can be observed. The improved wetting characteristics of wood surfaces coated with PHBHV and PHBHV.L is maintained higher than the control for about 45 min, and for PHBHV.LZnO for 60 min. Also, it can be highlighted, based on the CA variation, that samples containing the consolidates, L and L.ZnO, have a more stable and uniform surface; the contact angle decreases in the first 30 min by only 5.44% and 4.52%, respectively. The efficacy of ZnO grafted into lignin surface can be stated also based on the improvement in water repellency.
3.2.4. Antifungal Activity
Mold fungi (that include Penicillium spp., and Aspergillus spp.) are a class of fungi that usually degrade wood [3], favorized by moisture, that induce subsequent decay on wood. Most molds have aggressive action, with rapid growth, and are able to alter the esthetic value and main characteristics of the wood.
The antifungal activity is evaluated by measuring the diameter of the clear zone (halo) that appears around the samples. Also, the activity for films and wood specimens was evaluated based on the presence/absence of microbial growth on and under the samples. The results are presented in Table 3 and Table 4.
Table 3.
Antifungal activity of particles and PHBHV films.
Table 4.
Antifungal activity of coated wood.
The strong inhibitory action exerted by the L.ZnO sample against the two strains of filamentous tested fungi was noted. Thus, the diameter values decreased in the following order: P. chrysogenum (20 mm) > A. niger (17 mm), when the powders were spot inoculated. Lignin samples determined the inhibition only of the P. chrysogenum strain, especially for disk inoculation, where the inhibition diameter was 20 mm. For spot inoculation, only a significant reduction in the growth of the fungal strain was observed, probably due to a better diffusion of lignin by disk inoculation. P. chrysogenum was more sensitive to the inhibitory action of the tested samples, followed by A. niger which was somewhat more resistant especially for the lignin samples. The L.ZnO samples exerted good inhibitory action on the strain.
Knowing the antifungal mechanism of both ZnO and lignin, in case of the L.ZnO preservative used for oak wood protection, a synergistic antifungal effect can be considered: released Zn2+ ions, untaken by fungal cells, act rapidly to disrupt cell walls and generate a reactive oxygen species [61,62,63], and soda lignin enhances the action by further destabilizing membranes and interfering with internal fungal biochemistry due to its phenolic hydroxyl groups [64,65,66].
In case of films based on PHBHV, no clear zone of inhibition could be noticed, but upon their removal from the culture medium, no inoculated fungi were observed, thus resulting in a fungicidal action of the tested materials. Also, the materials were not covered by the tested microorganisms.
As expected, the control wood sample is affected by fungal growth, for both strains. The most representative image of the damage degree can be seen after 72 h of inhabitation. P. chrysogenum growth affected almost half of the sample’s high and A. niger is present also on the top of the specimen. The covering of wood with sporulated mycelium reflects the weak resistance of uncoated samples to fungal attack. The higher humidity value in the case of untreated wood can contribute to fungal growth, the degree of moisture being one of the main necessary conditions for fungi development [67,68].
Covering with PHBHV led to a small inhibition of fungal growth, but also in this case, the P. chrysogenum mycelium was still able to grow beneath the specimens. The inhibition of A. niger was achieved but was not complete. A similar tendency to partly inhibit the growth of both strains could be observed for the PHBHV.L coating, although soda lignin has no efficiency on these fungi [66]. Embedding it into the polymer matrix influences the antifungal action, being imparted by PHBHV.
The presence of L.ZnO nanoparticles in the coating composition reduced the fungal growth as compared with the control wood and previously described coatings. A synergy between the activity of both polymer and hybrid components of coating inhibited the mycelium development, being well-known for their antifungal activity [2,69,70]. In the case of P. chrysogenum, an inhibition zone close to the sample could be observed, and a halo of 20 mm after 24 h from inoculation. The clear zone can be observed also after 72 h, having about 18 mm in diameter. As a conclusion, PHBHV.LZnO can be considered a viable solution against fungi attack.
3.2.5. Thermal and UV Stability of Coatings
In Figure 9, the TGA/DTG curves of polymeric coatings are presented, with and without the studied preservatives. PHBHV presents only one weight loss process, between 180 and 280 °C and practically no char residue (0.93% probably due to some contained stabilizers). The temperature of the maximum loss rate (Tmax) was obtained in the first derivative curve, and has a value of 247.5 °C [15]. Using soda lignin into PHBHV matrix decreases the polymer thermal stability [55]. Thermal degradation of PHBHV occurs by chain scission and hydrolysis, resulting in polymers with a lower molecular weight and emergent crotonic acid [71,72].
Figure 9.
Thermal stability of polymer coatings.
The thermal degradation of PHBHV was slightly modified by soda lignin-based hybrids. The preservative addition leads to three stages of thermal degradation, in accordance with TGA curves of individual powders. The composites lose 2.2% for PHBHV.L and 1.5% for PHBHV.LZnO, respectively, until 150 °C due to the absorbed water. The first step of degradation is due to polymer decomposition, with the weight losses smaller with 7–9% than the neat polymer. The process occurs in a narrow temperature zone similar to the PHBHV process, but it is about 30 °C below that of pure PHBHV, indicating that the composites present lower thermal stability. The second degradation stage is imparted by the organic–inorganic powder, therefore L.ZnO slightly increases the polymer thermal stability, Tmax for PHBHV.LZnO is approx. 20 °C higher as compared with soda lignin embedded into the polymer matrix. One possible explanation could be based on the hydrolysis susceptibility of PHBHV in the presence of moisture; water is eliminated during the lignin-based hybrids and it could promote the cleavage of the polymeric chains and, consequently, polymer degradation [15,71]. Zn physical interactions and formed coordination structure stabilized the lignin chain and resulting thus more stable composite’s coatings.
The organic–inorganic hybrid embedded into the biodegradable polymer was tested as a UV protective layer for wood. Control and coated wooden specimens were irradiated for 420 h and the efficacy against radiation was analyzed by chromatic changes, FTIR, and contact angle measurements.
The colorimetric test was performed for irradiated samples and compared, by analyzing the delta values, with the native uncoated and coated specimens. The color parameters of control and coated wood sample varied with the irradiation time, Figure 10. The lightness of wood presented the highest variation, and its decrease was proportionally direct to the irradiation time. Lx* decreases rapidly for 120 h of irradiation, with 2.3 units, and slower until the final stage of the test when ΔLx* has a value of −2.5. This change in brightness is characteristic for photodegraded lignocellulosic surfaces [73,74]. As previously shown, applying the polymeric coating leads to a small difference in chromatic parameters, this being evidenced in Figure 10. Considering the initial values of parameters, it can be seen that the Lx* variation during the UV irradiation is not significant, with ΔLx* reaching only −0.9 units. By adding soda lignin, a similar variation of Lx* is observed, with a maximum delta value after 420 h of irradiation of 0.535 units. In the case of using L.ZnO hybrid into the coating system, the protection against UV can be seen in an almost constant variation in lightness.
Figure 10.
Variation in chromatic parameters after UV irradiation of samples for 420 h: (a) lightness; (b) red-green parameter; (c) yellow-blue parameter; (d) total color change of samples.
The ax* values of wood after UV treatment decrease with time, but not significantly in comparison with the native sample. After 420 h, Δax* reaches a value of only −0.4 units. The same variations can be observed for the coated samples, the change in the red-green parameter showed the best results for PHBHV.LZnO with a difference of −0.17 units.
The yellowing process of wood is demonstrated by the increase in the bx* parameter, Δbx* having positive values during the whole test, for all the specimens. For control, Δbx* increases from 0.3 at 30 h irradiation until 1.3 units at the final of the test [74]. The polymer improves the yellowing, and the yellow–blue coordinate value increases by maximum 0.55 units. When using soda lignin in the coating, the variation in yellowness is of maximum 0.43 units. As expected, L.ZnO-based coating protects the wood surface against UV degradation as can be evidenced by the almost constant variation of Δbx*.
The overall color difference after each interval of irradiation time is an important indicator that assesses the color change produced by a UV-degradation-accelerated test. It takes into consideration the variation in all the three coordinates, Lx*, ax*, and bx*, and it can offer a perspective image of the coating’s protection efficacy. For control, as previously observed, the first 120 h of irradiation brings the most important changes in wood color, although the ΔEx between 120 h and 420 h has a maximum value of 2.84, at the limit of color differences visible with a high quality screen, and it belongs to class three of the color scale proposed [75]. Similar color hue compared with the original one is observed for PHBHV coated wood. In this case, the total color change increases from 0.17 units at 30 h to 1.19 units at 420 h of irradiation. The ΔEx calculated for the PHBHV.L coating shows a higher chromatic variation, with values from 0.26 to 1.86 units. Invisible differences, when correlating to Lx*, ax*, bx* variations, is obtained for PHBHV.LZnO wood coating, the effect of the UV absorber being evident. The color stability of this sample also can highlight the protection of lignin into the system, probably due to the covering with ZnO nanoparticles showed by SEM [76].
The spectra of irradiated samples, in comparison with the initial FTIR absorption curves, are presented in Figure 11. The influence of UV radiation yields structural changes on wood surfaces. For the control sample, the “fingerprint region” of wood, the domain between 1800 and 800 cm−1, shows the main differences in FTIR spectra. The absorptions from 1593 and 1510 cm−1 of the aromatic skeletal vibration of lignin, 1456 cm−1 of C-H deformation in lignin, and 1267 cm−1 given by the C-O stretching in lignin ring in guaiacyl units decrease from the original value [77,78]. Also, changes in cellulose and hemicellulose bands are observed; increased intensities are recorded for the peaks centered at 1156 cm−1 and 1054 cm−1 with 10.9% and 9.5%, respectively. The absorption from 1104 cm−1 characteristic for the aromatic skeletal vibration and C-O stretching has an intensity higher with 8% than the non-irradiated sample [77]. Thus, the performed FTIR-ATR analysis highlights the wood sensitivity to UV irradiation based on the visible chemical changes.
Figure 11.
Structural changes recorded by FTIR on samples after UV irradiation. (a) 4000–2000 cm−1; (b) 2000–450 cm−1.
Important changes are observed in PHBHV coating’s spectrum after UV irradiation, showing strong photo-oxidation of the polymer, especially, in addition to the wood degradation. According to the literature, PHBHV is characterized both by crystalline zone, with peaks at 1717, 1267, 1223, and 972 cm−1, and amorphous ones, at 1740, 1453, and 1176 cm−1. The band from about 1720 cm−1 has, after irradiation, an increased intensity by 31% as compared to the non-irradiated coated wood surface. Three bands between 1280 and 1220 cm−1, narrow and more intense, are present in the FTIR spectrum, in contrast with the initial sample that has only a broad band at 1235 cm−1 associated with C-O stretching in ester groups. The new species with increased concentrations are generated by degradation via β-scission (Norrish type I reactions) [79]. The absorption from 1452 cm−1 presents a lower intensity and the peak from 1160 cm−1 is displaced to 1180 cm−1, so the amorphous zone is also affected by UV aging. The broad OH band of 3300 cm−1 is strongly changed due to the degradation reaction. In conclusion, PHBHV could not be considered a good coating material for wood, without proper additives or modification. Only small changes in peaks intensities are observed for PHBHV.L coating. Wood-specific peaks are less modified, so the UV radiation does not penetrate the polymeric layer and does not degrade the wooden support. Correlating with the chromatic variations, this result led to the conclusion that UV attacked the polymer first.
In the case of PHBHV.LZnO, the spectrum after UV irradiation could sustain the premise of being a good protective of wood surface. No major changes are observed, considering the characteristic bands of wood and polymeric matrix. The presence of the UV adsorber, characterized by the strong peak from 600 to 400 cm−1, leads to similar crystalline and amorphous peaks specific to PHBHV [71]. The UV radiation does not penetrate the coating as the characteristics peaks of wood are not changed.
The UV irradiation led to a decrease in surface hydrophobicity, as tested by contact angle measurement, as shown in Figure 12. For degraded wood, as previously demonstrated by the chromatic and structural changes, CA is reduced from 80.5° before irradiation to 70.18° after 420 h under UV light. PHBHV photo-oxidation leads also to a decrease in the contact angle value, transforming the coating into a wettable surface (CA 74.64°). Also, the polymer degradation decreases the contact angle for the PHBHV.L coating above the average between the polymer and hybrid values. The UV protection offered by L.ZnO-developed hybrids on wood is sustained by a decrease in the hydrophobicity by only 14.5%.
Figure 12.
Contact angle of irradiated samples. (a) Wood: 70.18°; (b) PHBHV: 74.64°; (c) PHBHV.L: 78.47°; (d) PHBHV.LZnO; 83.60°.
Taking into account the results on the synthesis and comprehensive characterization of the ZnO-lignin nanoparticles after lignin extraction from spent mushroom substrate, the formulation and application of the PHBHV-based coatings on the wood substrate, and an exhaustive assessment of the coated wood’s enhanced physicochemical, chromatic, UV-protective, and antifungal properties, the use of L.ZnO embedded into the biodegradable polymer can bring thereby an important contribution for developing sustainable wood protection and preservation technologies. The presented characterization study achieved on wood layers based on PHBHV and L.ZnO as sustainable and functional materials highlights that the efficacy of these polymer coatings makes them promising alternatives as wood protectives. These coatings perform multiple protective functions, such as acting as moisture barriers, UV protection, and good antifungal properties.
4. Conclusions
Conventional wood preservation techniques are usually based on synthetic resins, heavy metals and petroleum-derived compounds. Although effective to some extent, many of these methods raise concerns due to their environmental impact, toxicity, and limited reversibility—an important criterion in wood preservation and consolidation. As sustainability becomes a guiding principle in materials science, there is a growing demand for environmentally friendly solutions that can meet technical requirements while aligning with the principles of green chemistry.
In this context, a new method to prevent and diminish wood degradation and to increase its durability in various applications is studied. The paper aimed to demonstrate the efficiency of a coating developed based on a biodegradable polymer, poly(3-hydroxybutyrate-co-3-hydroxyvalerate) (PHBHV), and a soda lignin–ZnO hybrid obtained starting from spent mushroom substrate (SMS). The principle of the study was based on the reversibility of the coating imparted by the polymer biodegradability, compatibility with the substrate centered on using a lignin-based hybrid, and protection against fungi attack and UV radiation by adding ZnO—well-known for its beneficial antifungal and UV adsorber. Also, extracting lignin from SMS—an agricultural waste resulting in a large amount from mushroom cultivation and usually improperly disposed—contributes to eliminating a factor of environmental pollution and human health hazards.
The research established a methodological approach comprehending the characteristics of soda lignin extracted from SMS, the obtaining and complex analysis of lignin–ZnO decorated nanoparticles, the formulation and application of PHBHV-based coatings on wood substrates, and an in-depth evaluation of the improvement of coated wood physicochemical, chromatic, UV-protective, and antifungal properties. Together, these efforts can contribute to the advancement of sustainable technologies for wood protection and preservation.
For extracting lignin from SMS, the alkaline method was used due to the advantages regarding the commonly used chemical, in low amounts, reduced energy involved in the process, and the high yield of extraction, even at the industrial level. The statement was first sustained by lignin content determination that decreases from about 20% in SMS to only 2.26% in the extracted soda lignin. Furthermore, FTIR and Raman spectra, recorded before and after the process, sustained the separation of lignin from the other two polysaccharides—cellulose and hemicellulose. The structural and compositional analysis highlighted the weak interactions established between organic and inorganic phases and the physical adsorption on the decorative support. The results were confirmed by XPS analysis where carbonyl coordination and strong hydrogen bonding were evidenced. Grafting ZnO on soda lignin’s surface improves thermal stability by increasing decomposition temperature and slowing down the degradation rate. ESEM images showed a more compact surface, mostly spherical and rod-shaped crystals uniformly dispersed on the substrate surface. The formed interactions led to filled interstitial spaces and lignin pores.
The solution developed in this study based on poly(3-hydroxybutyrate-co-3-hydroxyvalerate) and lignin–ZnO was applied to oak wood specimens by brushing; the improvement of hydrophobicity and protection against UV and fungal attack, while maintaining the color of the samples, were demonstrated. A uniform dispersion of L.ZnO nanoparticles was observed, with a core–shell structure formed by ZnO grafted on soda lignin surface. The formed coating ensures a smooth and less porous wood surface. The small increase in preservative retention in the case of using L.ZnO, leading to a better penetration into the wood pores and surface isolation, can be correlated with a water absorption of 48.8% lower than the control sample, a humidity of only 4.734% as compared to native wood which is characterized by a value of 34.911%, and a contact angle of 97.8°, making the transition from hydrophilic to hydrophobic surface. The total color change is maintained in the tolerance range of color shift.
The thermal stability of PHBHV is slightly affected by using grafted ZnO nanoparticles. The presence of L.ZnO nanoparticles in the coating composition reduced the fungal growth of Penicillium chrysogenum and Aspergillus niger as compared with the control wood samples. So PHBHV.LZnO can be considered a viable solution against fungi attack.
Control and coated wooden specimens were irradiated for 420 h and the efficacy against radiation was analyzed by chromatic changes, FTIR, and contact angle measurements. Almost constant variations in lightness, redness and yellowness, and a total color change are measured, the effect of the UV absorber being evident during the degradation accelerated test. The FTIR spectrum after UV irradiation for 420 h showed no major changes considering the characteristic bands of wood and polymeric matrix, and sustained the premise of being a good protective of wood surface, considering both lignin and L.ZnO contributions. The UV radiation does not penetrate the PHBHV–LZnO coating as the characteristic peaks of wood do not change. The UV protection offered by L.ZnO on the wood surface was sustained also by a small decrease in the hydrophobicity unlike native wood.
Thus, polymer coatings based on sustainable and functional materials have emerged as promising alternatives. These coatings perform multiple protective functions, such as acting as moisture barriers and good antifungal properties.
Author Contributions
Conceptualization, R.M.G., R.-M.I. and L.I.; methodology, R.M.G.; software, R.M.G.; validation, R.M.G., R.-M.I. and L.I.; formal analysis, R.M.G.; investigation, R.M.G., R.-M.I., L.I., S.S.-T., A.I.G., E.A., M.E.D., M.C., I.R., C.M.D., C.-A.N. and B.T.; resources, R.-M.I. and R.M.G.; writing—original draft preparation, R.M.G.; writing—review and editing, R.-M.I. and L.I.; visualization, R.M.G. and L.I.; supervision, R.-M.I.; project administration, R.-M.I. and R.M.G.; funding acquisition, R.-M.I. All authors have read and agreed to the published version of the manuscript.
Funding
This research received no external funding.
Institutional Review Board Statement
Not applicable.
Informed Consent Statement
Not applicable.
Data Availability Statement
The raw data supporting the conclusions of this article will be made available by the authors on request.
Acknowledgments
This work was supported by a grant of the Romanian Ministry of Education and Research, National Authority for Scientific Research (ANC), Nucleu project PN 23.06.02.01—InteGral.
Conflicts of Interest
The authors declare no conflicts of interest.
Correction Statement
This article has been republished with a minor correction to the reference 53. This change does not affect the scientific content of the article.
References
- Alfieri, P.V.; Lofeudo, R.; Canosa, G. Impregnant formulation to the preservation, protection and consolidation of wood heritage assets. Int. J. Conserv. Sci. 2018, 9, 629–640. [Google Scholar]
- David, M.E.; Ion, R.-M.; Grigorescu, R.M.; Iancu, L.; Constantin, M.; Stirbescu, R.M.; Gheboianu, A.I. Wood Surface Modification with Hybrid Materials Based on Multi-Walled Carbon Nanotubes. Nanomaterials 2022, 12, 1990. [Google Scholar] [CrossRef] [PubMed]
- Teacă, C.-A.; Roşu, D.; Mustaţă, F.; Rusu, T.; Roşu, L.; Roşca, I.; Varganici, C.-D. Natural Bio-Based Products for Wood Coating and Protection against Degradation: A Review. BioResources 2019, 14, 4873–4901. [Google Scholar] [CrossRef]
- Rowell, R.M. Chemical modification of wood: A short review. Wood Mater. Sci. Eng. 2006, 1, 29–33. [Google Scholar] [CrossRef]
- Favaro, M.; Mendichi, R.; Ossola, F.; Russo, U.; Simon, S.; Tomasin, P.; Vigato, P.A. Evaluation of polymers for conservation treatments of outdoor exposed stone monuments. Part I: Photo-oxidative weathering. Polym. Degrad. Stab. 2006, 91, 3083–3096. [Google Scholar] [CrossRef]
- Salla, J.; Pandey, K.K.; Srinivas, K. Improvement of UV resistance of wood surfaces by using ZnO nanoparticles. Polym. Degrad. Stab. 2012, 97, 592–596. [Google Scholar] [CrossRef]
- Manoudis, P.N.; Karapanagiotis, I.; Tsakalof, A.; Zuburtikudis, I.; Kolinkeova, B.; Panayiotou, C. Superhydrophobic films for the protection of outdoor cultural heritage assets. Appl. Phys. A-Mater. Sci. Process. 2009, 97, 351–360. [Google Scholar] [CrossRef]
- Tuduce-Traistaru, A.-A.; Campean, M.; Timar, M.C. Compatibility indicators in developing consolidation materials with nanoparticle insertions for old wooden objects. Int. J. Conserv. Sci. 2010, 1, 219–226. [Google Scholar]
- Abbasi, J.; Samanian, K.; Afsharpor, M. Evaluation of Polvinyl butyral and zinc oxide nanocomposite for consolidation of historical woods. Int. J. Conserv. Sci. 2017, 8, 207–214. [Google Scholar]
- Khanna, S.; Srivastava, A.K. Recent advances in microbial polyhydroxyalkanoates. Process Biochem. 2005, 40, 607–619. [Google Scholar] [CrossRef]
- Bugnicourt, E.; Cinelli, P.; Alvarez, V.; Lazzeri, A. Polyhydroxyalkanoate (PHA): Review of synthesis, characteristics, processing and potential applications in packaging. Express Polym. Lett. 2014, 8, 791–808. [Google Scholar] [CrossRef]
- Chen, G.-Q. Plastics Completely Synthesized by Bacteria: Polyhydroxyalkanoates. In Plastics from Bacteria: Natural Functions and Applications; Chen, G.G.-Q., Ed.; Springer: Berlin/Heidelberg, Germany, 2010; pp. 17–37. [Google Scholar]
- Andreotti, S.; Franzoni, E.; Esposti, M.D.; Fabbri, P. Poly(hydroxyalkanoate)s-Based Hydrophobic Coatings for the Protection of Stone in Cultural Heritage. Materials 2018, 11, 165. [Google Scholar] [CrossRef] [PubMed]
- Rivera-Briso, A.L.; Serrano-Aroca, Á. Poly(3-Hydroxybutyrate-co-3-Hydroxyvalerate): Enhancement Strategies for Advanced Applications. Polymers 2018, 10, 732. [Google Scholar] [CrossRef] [PubMed]
- Lemes, A.P.; Soto-Oviedo, M.; Waldman, W.; Innocentini-Mei, L.; Durán, N. Effect of lignosulfonate on the thermal and morphological behavior of poly (3-hydroxybutyrate-co-3-hydroxyvalerate). J. Polym. Environ. 2010, 18, 250–259. [Google Scholar] [CrossRef]
- Grigore, M.E.; Grigorescu, R.M.; Iancu, L.; Ion, R.-M.; Zaharia, C.; Andrei, E.R. Methods of synthesis, properties and biomedical applications of polyhydroxyalkanoates: A review. J. Biomater. Sci. Polym. Ed. 2019, 30, 695–712. [Google Scholar] [CrossRef] [PubMed]
- Chan, C.M.; Pratt, S.; Halley, P.; Richardson, D.; Werker, A.; Laycock, B.; Vandi, L.-J. Mechanical and physical stability of polyhydroxyalkanoate (PHA)-based wood plastic composites (WPCs) under natural weathering. Polym. Test. 2019, 73, 214–221. [Google Scholar] [CrossRef]
- Hussien Ali, A.; Moghadam, P.N.; Faris, A.H.; Abdullah, M.Z. Synthesis and Characterization of Titanium Dioxide (TiO2) and Zinc Oxide (ZnO) Nanoparticles to Encapsulated Soda Lignin Polymer. J. Appl. Organomet. Chem. 2024, 4, 338–348. [Google Scholar] [CrossRef]
- Vasile, C.; Baican, M. Lignins as Promising Renewable Biopolymers and Bioactive Compounds for High-Performance Materials. Polymers 2023, 15, 3177. [Google Scholar] [CrossRef] [PubMed]
- Boarino, A.; Klok, H.A. Opportunities and Challenges for Lignin Valorization in Food Packaging, Antimicrobial, and Agricultural Applications. Biomacromolecules 2023, 24, 1065–1077. [Google Scholar] [CrossRef] [PubMed]
- Bhat, R.; Abdullah, N.; Din, R.H.; Tay, G.-S. Producing novel sago starch based food packaging films by incorporating lignin isolated from oil palm black liquor waste. J. Food Eng. 2013, 119, 707–713. [Google Scholar] [CrossRef]
- Makri, S.P.; Xanthopoulou, E.; Valera, M.A.; Mangas, A.; Marra, G.; Ruiz, V.; Koltsakidis, S.; Tzetzis, D.; Zoikis Karathanasis, A.; Deligkiozi, I.; et al. Poly(Lactic Acid) Composites with Lignin and Nanolignin Synthesized by In Situ Reactive Processing. Polymers 2023, 15, 2386. [Google Scholar] [CrossRef] [PubMed]
- Taher, M.A.; Wang, X.; Hasan, K.M.F.; Miah, M.; Zhu, J.; Chen, J. Lignin Modification for Enhanced Performance of Polymer Composites. ACS Appl. Bio Mater. 2023, 6, 5169–5192. [Google Scholar] [CrossRef] [PubMed]
- Atallah, E.; Zeaiter, J.; Ahmad, M.N.; Leahy, J.J.; Kwapinski, W. Hydrothermal carbonization of spent mushroom compost waste compared against torrefaction and pyrolysis. Fuel Process. Technol. 2021, 216, 106795. [Google Scholar] [CrossRef]
- Ma, X.; Yan, S.; Wang, M. Spent mushroom substrate: A review on present and future of green applications. J. Environ. Manag. 2025, 373, 123970. [Google Scholar] [CrossRef] [PubMed]
- Leong, Y.K.; Ma, T.-W.; Chang, J.-S.; Yang, F.-C. Recent advances and future directions on the valorization of spent mushroom substrate (SMS): A review. Bioresour. Technol. 2022, 344, 126157. [Google Scholar] [CrossRef] [PubMed]
- Rao, W.; Zhang, D.; Guan, X.; Pan, X. Recycling of spent mushroom substrate biowaste as an Anti-UV agent for Bacillus thuringiensis. Sustain. Chem. Pharm. 2022, 30, 100811. [Google Scholar] [CrossRef]
- Beckers, S.J.; Dallo, I.A.; del Campo, I.; Rosenauer, C.; Klein, K.; Wurm, F.R. From Compost to Colloids—Valorization of Spent Mushroom Substrate. ACS Sustain. Chem. Eng. 2019, 7, 6991–6998. [Google Scholar] [CrossRef]
- Adi, M.R.M.; Izhar, T.N.T.; Ibrahim, N.M.; Aziz, N.A.; Hadiyanto, H.; Matei, M. The Effect of Chemical Treated Spent Mushroom Substrate (SMS) on Lignocellulosic Content. IOP Conf. Ser. Earth Environ. Sci. 2023, 1216, 012015. [Google Scholar] [CrossRef]
- Singh, S.K.; Dhepe, P.L. Isolation of lignin by organosolv process from different varieties of rice husk: Understanding their physical and chemical properties. Bioresour. Technol. 2016, 221, 310–317. [Google Scholar] [CrossRef] [PubMed]
- Liu, M. Application of Aspergillus Niger in the resourcable utilization of straw. IOP Conf. Ser. Earth Environ. Sci. 2021, 859, 012092. [Google Scholar] [CrossRef]
- Karuppan Perumal, M.K.; Rajasekaran, M.B.S.; Rajan Renuka, R.; Samrot, A.V.; Nagarajan, M. Zinc oxide nanoparticles and their nanocomposites as an imperative coating for smart food packaging. Appl. Food Res. 2025, 5, 100849. [Google Scholar] [CrossRef]
- Mohd Yusof, H.; Mohamad, R.; Zaidan, U.H.; Abdul Rahman, N.A. Microbial synthesis of zinc oxide nanoparticles and their potential application as an antimicrobial agent and a feed supplement in animal industry: A review. J. Anim. Sci. Biotechnol. 2019, 10, 57. [Google Scholar] [CrossRef] [PubMed]
- Cuadra, J.G.; Scalschi, L.; Vicedo, B.; Guc, M.; Izquierdo-Roca, V.; Porcar, S.; Fraga, D.; Carda, J.B. ZnO/Ag Nanocomposites with Enhanced Antimicrobial Activity. Appl. Sci. 2022, 12, 5023. [Google Scholar] [CrossRef]
- Zhou, X.-Q.; Hayat, Z.; Zhang, D.-D.; Li, M.-Y.; Hu, S.; Wu, Q.; Cao, Y.-F.; Yuan, Y. Zinc Oxide Nanoparticles: Synthesis, Characterization, Modification, and Applications in Food and Agriculture. Processes 2023, 11, 1193. [Google Scholar] [CrossRef]
- Zhang, Z.; Terrasson, V.; Guénin, E. Lignin Nanoparticles and Their Nanocomposites. Nanomaterials 2021, 11, 1336. [Google Scholar] [CrossRef] [PubMed]
- Tang, Q.; Qian, Y.; Yang, D.; Qiu, X.; Qin, Y.; Zhou, M. Lignin-Based Nanoparticles: A Review on Their Preparations and Applications. Polymers 2020, 12, 2471. [Google Scholar] [CrossRef] [PubMed]
- Kirar, S.; Mohne, D.; Singh, M.; Sagar, V.; Bhise, A.; Goswami, S.; Bhaumik, J. Eco-friendly lignin nanocomposite films as advanced UV protective and antimicrobial sustainable packaging materials. Sustain. Mater. Technol. 2024, 40, e00864. [Google Scholar] [CrossRef]
- Tuduce Trǎistaru, A.-A.; Crina Anca Sandu, I.; Cristina Timar, M.; Lucia Dumitrescu, G.; Sandu, I. SEM-EDX, water absorption, and wetting capability studies on evaluation of the influence of nano-zinc oxide as additive to paraloid B72 solutions used for wooden artifacts consolidation. Microsc. Res. Tech. 2013, 76, 209–218. [Google Scholar] [CrossRef] [PubMed]
- ASTM D2244; Standard Practice for Calculation of Color Tolerances and Color Differences from Instrumentally Measured Color Coordinates. ASTM International: West Conshohocken, PA, USA, 2013.
- Aurélien, S.; Daniel, S. Drop Shape Analysis. Available online: https://bigwww.epfl.ch/demo/dropanalysis/ (accessed on 14 April 2025).
- Horikawa, Y.; Hirano, S.; Mihashi, A.; Kobayashi, Y.; Zhai, S.; Sugiyama, J. Prediction of Lignin Contents from Infrared Spectroscopy: Chemical Digestion and Lignin/Biomass Ratios of Cryptomeria japonica. Appl. Biochem. Biotechnol. 2019, 188, 1066–1076. [Google Scholar] [CrossRef] [PubMed]
- Ab Rahim, A.H.; Man, Z.; Sarwono, A.; Wan Hamzah, W.; Mohamad Yunus, N.; Wilfred, C. Extraction and Comparative Analysis of Lignin Extract from Alkali and Ionic Liquid Pretreatment. J. Phys. Conf. Ser. 2018, 1123, 012052. [Google Scholar] [CrossRef]
- Akpakpan, A.; Edu, J.; Ita, B.; Akpabio, U. Physicochemical Properties of Soda and Kraft Lignin Extracted from Gmelina arborea Wood. Int. Res. J. Pure Appl. Chem. 2023, 24, 9–19. [Google Scholar] [CrossRef]
- Wang, H.; Qiu, X.; Liu, W.; Fu, F.; Yang, D. A Novel Lignin/ZnO Hybrid Nanocomposite with Excellent UV-Absorption Ability and Its Application in Transparent Polyurethane Coating. Ind. Eng. Chem. Res. 2017, 56, 11133–11141. [Google Scholar] [CrossRef]
- Zhang, L.; Wang, Y.; Yang, D.; Wang, H.; Liu, W.; Li, Z. Multilayer two-dimensional lignin/ZnO composites with excellent anti-UV aging properties for polymer films. Green Chem. Eng. 2022, 3, 338–348. [Google Scholar] [CrossRef]
- Yue, X.; Suopajärvi, T.; Sun, S.; Mankinen, O.; Mikkelson, A.; Huttunen, H.; Komulainen, S.; Romakkaniemi, I.; Ahola, J.; Telkki, V.-V.; et al. High-purity lignin fractions and nanospheres rich in phenolic hydroxyl and carboxyl groups isolated with alkaline deep eutectic solvent from wheat straw. Bioresour. Technol. 2022, 360, 127570. [Google Scholar] [CrossRef] [PubMed]
- Jose, L.M.; Kuriakose, S.; Thomas, S. Fabrication, Characterization and In Vitro Antifungal Property Evaluation of Biocompatible Lignin-Stabilized Zinc Oxide Nanoparticles Against Selected Pathogenic Fungal Strains. BioNanoScience 2020, 10, 583–596. [Google Scholar] [CrossRef]
- Aiduang, W.; Jatuwong, K.; Kiatsiriroat, T.; Kamopas, W.; Tiyayon, P.; Jawana, R.; Xayyavong, O.; Lumyong, S. Spent Mushroom Substrate-Derived Biochar and Its Applications in Modern Agricultural Systems: An Extensive Overview. Life 2025, 15, 317. [Google Scholar] [CrossRef] [PubMed]
- Jordan, S.N.; Mullen, G.J.; Murphy, M.C. Composition variability of spent mushroom compost in Ireland. Bioresour. Technol. 2008, 99, 411–418. [Google Scholar] [CrossRef] [PubMed]
- Del Buono, D.; Luzi, F.; Tolisano, C.; Puglia, D.; Di Michele, A. Synthesis of a Lignin/Zinc Oxide Hybrid Nanoparticles System and Its Application by Nano-Priming in Maize. Nanomaterials 2022, 12, 568. [Google Scholar] [CrossRef] [PubMed]
- Bhuiyan, M.; Mamur, H. A Brief Review of the Synthesis of ZnO Nanoparticles for Biomedical Applications. Iran. J. Mater. Sci. Eng. 2021, 18, 1–27. [Google Scholar] [CrossRef]
- Hosseini, S.A.; Babaei, S. Graphene Oxide/Zinc Oxide (GO/ZnO) Nanocomposite as a Superior Photocatalyst for Degradation of Methylene Blue (MB)-Process Modeling by Response Surface Methodology (RSM). J. Braz. Chem. Soc. 2016, 28, 299–307, Retraction in J. Braz. Chem. Soc. 2025, 36, 9. [Google Scholar] [CrossRef]
- Naseer, H.; Al-Zaqri, N.; Iqbal, T.; Yousaf, M.; Afsheen, S.; Sultan, M.S.; Warad, I.; Farooq, M.; Masood, A. Investigation of Mg Doped ZnO Nanoparticles Decorated with Ag for Efficient Photocatalytic Degradation. J. Inorg. Organomet. Polym. Mater. 2023, 33, 2790–2802. [Google Scholar] [CrossRef]
- Shichao, W.; Hengxue, X.; Renlin, W.; Zhe, Z.; Meifang, Z. Influence of amorphous alkaline lignin on the crystallization behavior and thermal properties of bacterial polyester. J. Appl. Polym. Sci. 2015, 132, 41325. [Google Scholar] [CrossRef]
- Adjaoud, A.; Dieden, R.; Verge, P. Sustainable Esterification of a Soda Lignin with Phloretic Acid. Polymers 2021, 13, 637. [Google Scholar] [CrossRef] [PubMed]
- Iancu, L.; Grigorescu, R.M.; Ion, R.-M.; David, M.E.; Slamnoiu-Teodorescu, S. The Effect of UV Irradiation on the Stability of Coated Fir Wood Samples. Sci. Bull. ‘Valahia’ Univ. Mater. Mech. 2022, 18, 8–14. [Google Scholar] [CrossRef]
- Dvořák, O.; Kvietková, M.S.; Šimůnková, K.; Machanec, O.; Pánek, M.; Pastierovič, F.; Lin, C.-F.; Jones, D. The Influence of the Initial Treatment of Oak Wood on Increasing the Durability of Exterior Transparent Coating Systems. Polymers 2023, 15, 3251. [Google Scholar] [CrossRef] [PubMed]
- Hui, Z.; Haonan, Z.; Hao, R.; Huamin, Z. Optimized preparation of spruce kraft lignin/ZnO composites and their performance analysis in polyurethane films. Int. J. Biol. Macromol. 2022, 209, 1465–1476. [Google Scholar] [CrossRef] [PubMed]
- Zare, M.; Keerthiraj, D.N.; Ilyas, S.; Hezam, A.; Mathur, D.S.; Byrappa, K. Smart Fortified PHBV-CS Biopolymer with ZnO−Ag Nanocomposites for Enhanced Shelf Life of Food Packaging. ACS Appl. Mater. Interfaces 2019, 11, 48309–48320. [Google Scholar] [CrossRef] [PubMed]
- Pasquet, J.; Chevalier, Y.; Pelletier, J.; Couval, E.; Bouvier, D.; Bolzinger, M.-A. The contribution of zinc ions to the antimicrobial activity of zinc oxide. Colloids Surf. A Physicochem. Eng. Asp. 2014, 457, 263–274. [Google Scholar] [CrossRef]
- Vargas Hernández, R.; Alvarez Lemus, M.A.; De la Rosa García, S.; López González, R.; Quintana, P.; García Zaleta, D.; Velázquez Vázquez, V.; Gómez Cornelio, S. Antifungal Activity of ZnO Nanoparticles Synthesized from Eichhornia crassipes Extract for Construction Applications. Nanomaterials 2024, 14, 1007. [Google Scholar] [CrossRef] [PubMed]
- Vitasovic, T.; Caniglia, G.; Eghtesadi, N.; Ceccato, M.; Jesen, E.; Gosewinkel, U.; Neusser, G.; Rupp, U.; Walther, P.; Kranz, C.; et al. Antibacterial Action of Zn2+ Ions Driven by the In Vivo Formed ZnO Nanoparticles. ACS Appl. Mater. Interfaces 2024, 16, 30847–30859. [Google Scholar] [CrossRef] [PubMed]
- Nada, A.; El-Diwany, A.; Elshafei, A. Infrared and antimicrobial studies on different lignins. Acta Biotechnol. 1989, 9, 295–298. [Google Scholar] [CrossRef]
- Sunthornvarabhas, J.; Liengprayoon, S.; Suwonsichon, T. Antimicrobial kinetic activities of lignin from sugarcane bagasse for textile product. Ind. Crops Prod. 2017, 109, 857–861. [Google Scholar] [CrossRef]
- Reyes, D.C.; Ma, Z.; Romero, J.J. The Antimicrobial Properties of Technical Lignins and Their Derivatives—A Review. Polymers 2024, 16, 2181. [Google Scholar] [CrossRef] [PubMed]
- Lebow, S.T. Wood preservation. In Wood Handbook: Wood as an Engineering Material, Centennial ed.; General technical report FPL.; GTR-190; Chapter 15; US Department of Agriculture, Forest Service, Forest Products Laboratory: Madison, WI, USA, 2010; Volume 190, pp. 15.1–15.28. [Google Scholar]
- Food and Agriculture Organization of the United Nations Mechanical Wood Products Branch. Wood Preservation Manual; Food and Agriculture Organization of the United Nations: Rome, Italy, 1986. [Google Scholar]
- Erazo, A.; Mosquera, S.A.; Rodríguez-Paéz, J.E. Synthesis of ZnO nanoparticles with different morphology: Study of their antifungal effect on strains of Aspergillus niger and Botrytis cinerea. Mater. Chem. Phys. 2019, 234, 172–184. [Google Scholar] [CrossRef]
- Ardiansyah, R.; Santoso, I. The effect of zinc oxide nanoparticles against ceiling mold isolate. IOP Conf. Ser. Earth Environ. Sci. 2020, 481, 012017. [Google Scholar] [CrossRef]
- Öner, M.; Kılıç, B.; Sudurağı, M.; Abamor, E.Ş.; Akgül, B.; Üner, B.K. Development of hybrid bionanocomposites of poly (3-hydroxybutyrate-co-3-hydroxyvalerate) with zinc oxide and silicon-doped hydroxyapatite nanocrystals and machine learning for predicting dynamic mechanical properties. Int. J. Biol. Macromol. 2025, 294, 139338. [Google Scholar] [CrossRef] [PubMed]
- Camargo, F.A.; Innocentini-Mei, L.H.; Lemes, A.P.; Moraes, S.G.; Durán, N. Processing and characterization of composites of poly (3-hydroxybutyrate-co-hydroxyvalerate) and lignin from sugar cane bagasse. J. Compos. Mater. 2012, 46, 417–425. [Google Scholar] [CrossRef]
- Müller, U.; Rätzsch, M.; Schwanninger, M.; Steiner, M.; Zöbl, H. Yellowing and IR-changes of spruce wood as result of UV-irradiation. J. Photochem. Photobiol. B Biol. 2003, 69, 97–105. [Google Scholar] [CrossRef] [PubMed]
- Kúdela, J.; Ihracký, P.; Kačík, F. Discoloration and Surface Changes in Spruce Wood after Accelerated Aging. Polymers 2024, 16, 1191. [Google Scholar] [CrossRef] [PubMed]
- Allegretti, O.; Travan, L.; Cividini, R. Drying techniques to obtain white beech. In Proceedings of the Wood EDG Conference, Bled, Slovenia, 23 April 2009; pp. 7–13. [Google Scholar]
- Palija, T.; Dobić, J.; Jaić, M. A photochemical method for improvement of color stability at polymer–wood biointerfaces. Colloids Surf. B Biointerfaces 2013, 108, 152–157. [Google Scholar] [CrossRef] [PubMed]
- Geffertová, J.; Geffert, A.; Výbohová, E. The effect of UV irradiation on the colour change of the spruce wood. Acta Fac. Xylologiae Zvolen Res Publica Slovaca 2018, 60, 41–50. [Google Scholar]
- Cogulet, A.; Blanchet, P.; Landry, V. Wood degradation under UV irradiation: A lignin characterization. J. Photochem. Photobiol. B Biol. 2016, 158, 184–191. [Google Scholar] [CrossRef] [PubMed]
- Wei, L.; McDonald, A.G. Accelerated weathering studies on the bioplastic, poly (3-hydroxybutyrate-co-3-hydroxyvalerate). Polym. Degrad. Stab. 2016, 126, 93–100. [Google Scholar] [CrossRef]
Disclaimer/Publisher’s Note: The statements, opinions and data contained in all publications are solely those of the individual author(s) and contributor(s) and not of MDPI and/or the editor(s). MDPI and/or the editor(s) disclaim responsibility for any injury to people or property resulting from any ideas, methods, instructions or products referred to in the content. |
© 2025 by the authors. Licensee MDPI, Basel, Switzerland. This article is an open access article distributed under the terms and conditions of the Creative Commons Attribution (CC BY) license (https://creativecommons.org/licenses/by/4.0/).